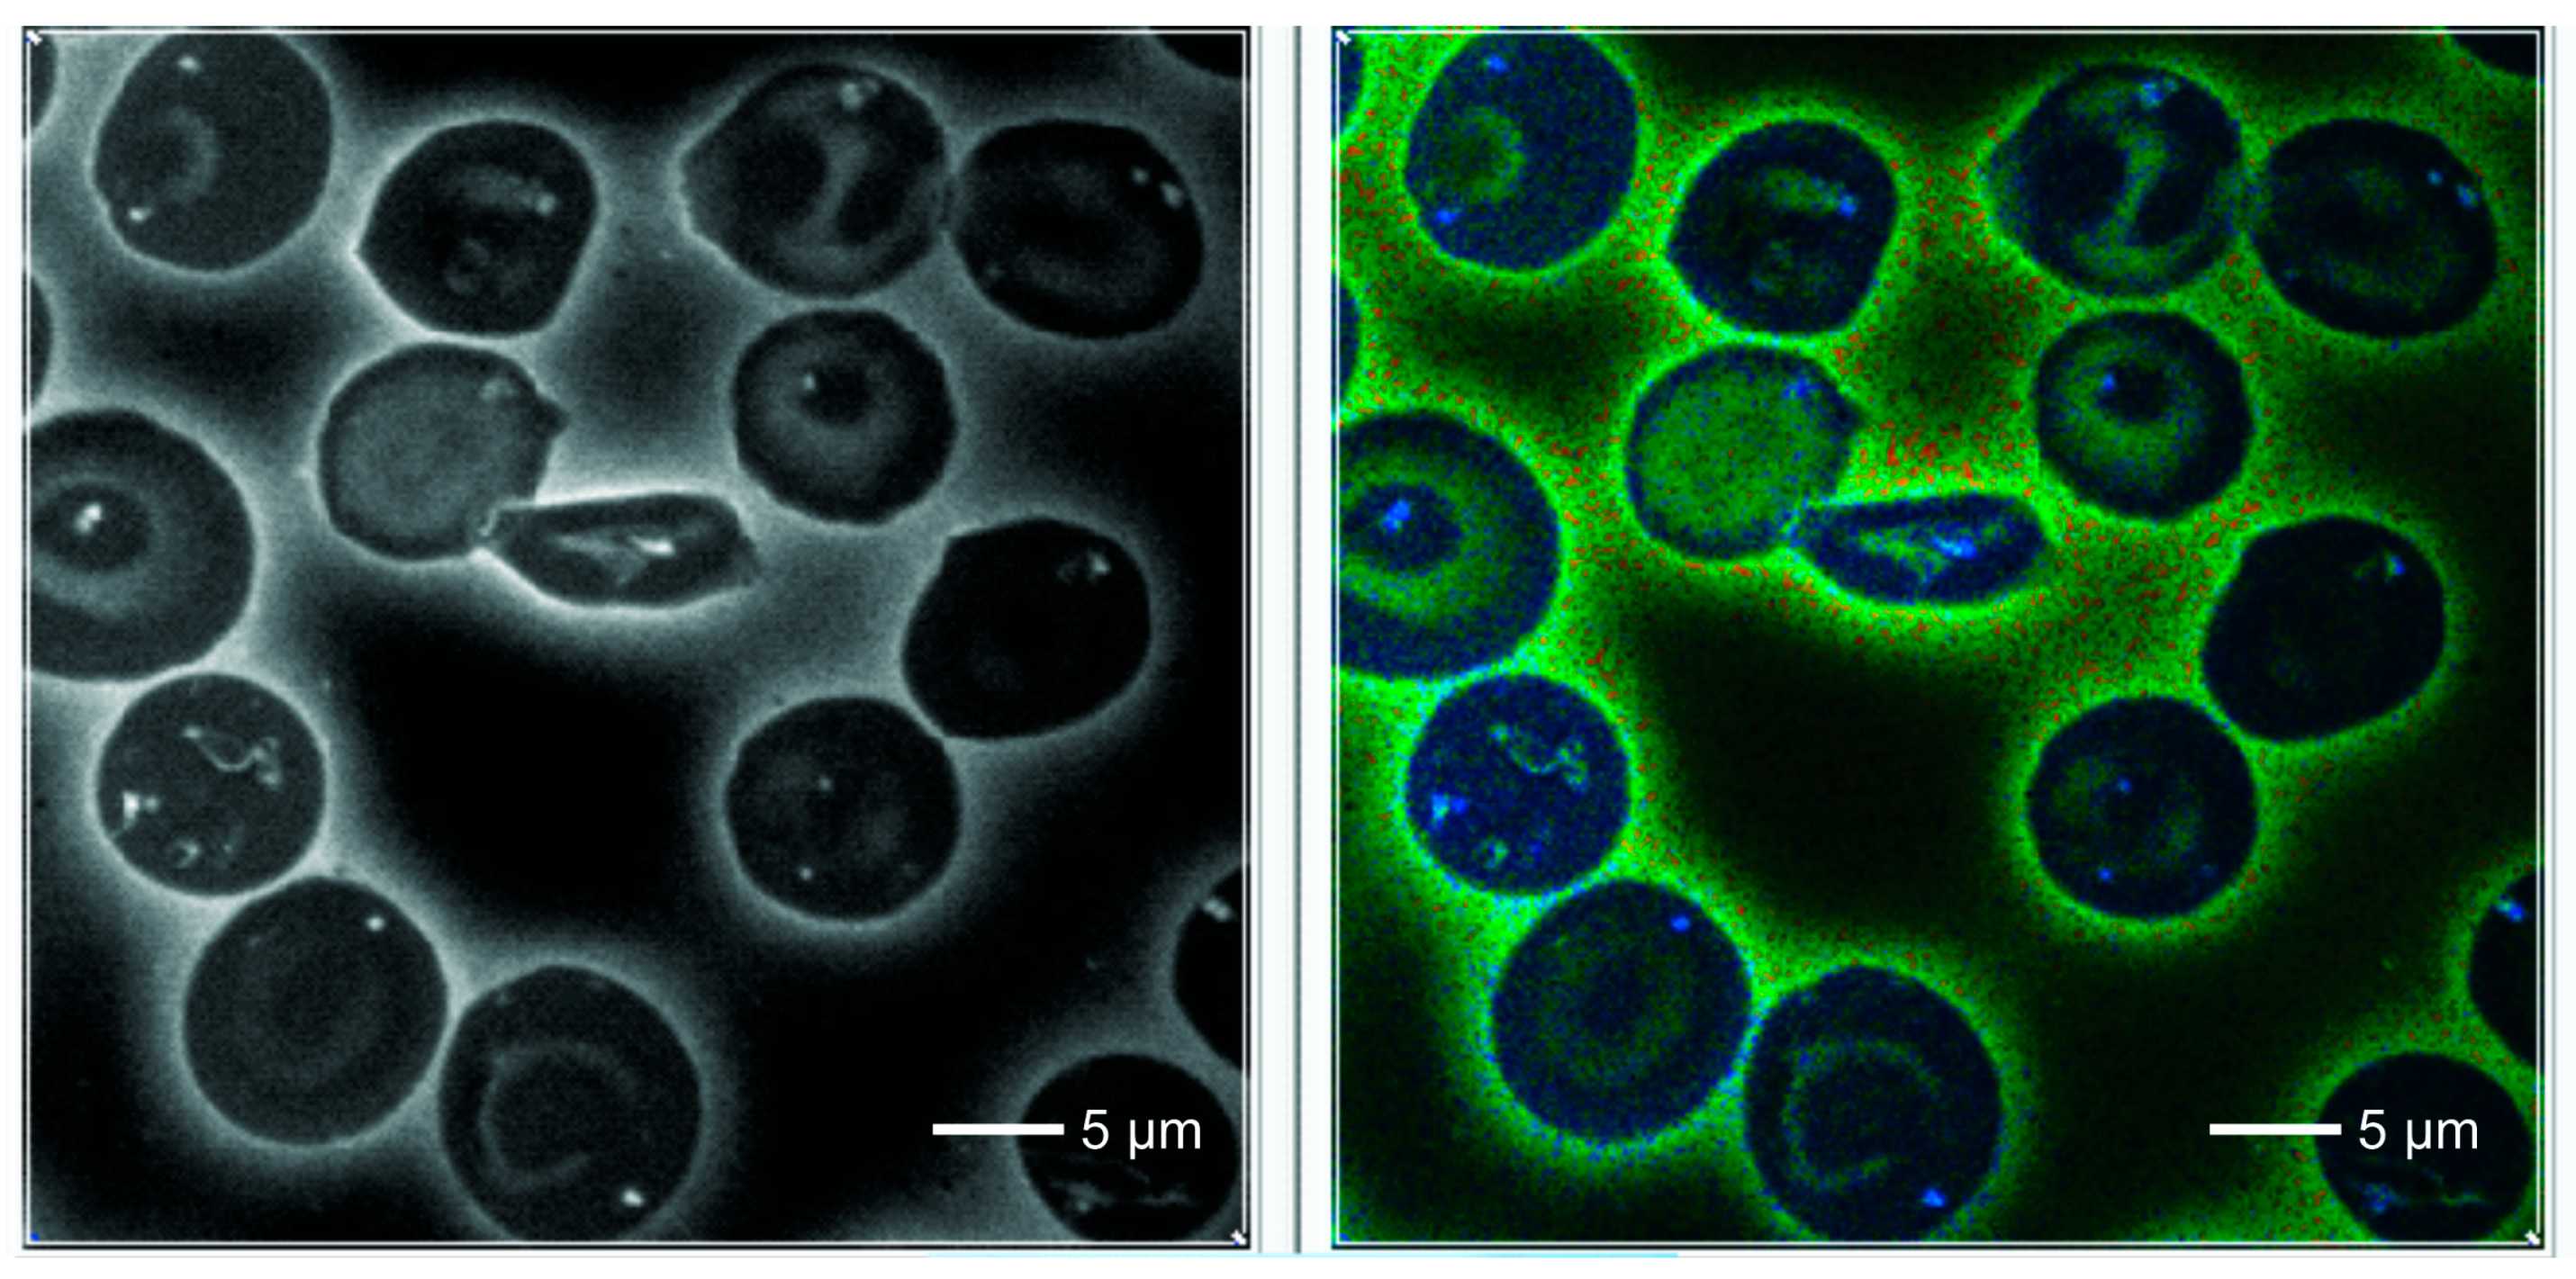
Ijms 25 12290 g003

Accompanying Hemoglobin Polymerization in Red Blood Cells in Patients with Sickle Cell Disease Using Fluorescence Lifetime Imaging
Abstract
1. Introduction
2. Results
3. Discussion
4. Material and Methods
4.1. Patients
4.2. Techniques
4.3. Local Binary Patterns
4.4. Linear Discriminant Classifier
4.5. Statistical Analysis
Author Contributions
Funding
Institutional Review Board Statement
Data Availability Statement
Acknowledgments
Conflicts of Interest
References
- Kato, G.J.; Piel, F.B.; Reid, C.D.; Gaston, M.H.; Ohene-Frempong, K.; Krishnamurti, L.; Smith, V.R.; Panepinto, J.A.; Weatherall, D.J.; Costa, F.F.; et al. Sickle cell disease. Nat. Rev. Dis. Primers 2022, 4, 1–22. [Google Scholar] [CrossRef] [PubMed]
- Eaton, W.A.; Bunn, H.F. Treating sickle cell disease by targeting HbS polymerization. Blood 2017, 129, 2719–2726. [Google Scholar] [CrossRef] [PubMed]
- Lei, H.; Karniadakis, G.E. Multiscale modeling of sickle cell anemia. In Modeling the Heart and the Circulatory System; Quarteroni, A., Ed.; Springer: Berlin/Heidelberg, Germany, 2015; pp. 119–156. [Google Scholar]
- Lu, L.; Li, H.; Li, X.; Karniadakis, G.E. Mesoscopic adaptative resolution scheme toward understanding of interactions between sickle cell fibers. Biophys. J. 2017, 113, 48–59. [Google Scholar] [CrossRef] [PubMed]
- Bukara, K.; Jovanic, S.; Drvenica, I.T.; Stancic, A.; Ilic, V.; Rabasovic, M.D.; Pantelic, D.; Jelenkovic, B.; Bugarski, B.; Krmpot, A.J. Mapping of hemoglobin in erythrocytes and erythrocyte ghosts using two photon excitation fluorescence microscopy. J. Biomed. Opt. 2017, 22, 026003. [Google Scholar] [CrossRef] [PubMed]
- Radmilovic, M.D.; Drvenica, I.T.; Rabasovic, M.D.; Ilic, V.L.; Pavlovic, D.; Oasa, S.; Vukojevic, V.; Peric, M.; Nikolic, S.N.; Krmpot, A.J. Interactions of ultrashort laser pulses with hemoglobin: Photophysical aspects and potential applications. Int. J. Biol. Macromolec. 2023, 244, 125312. [Google Scholar] [CrossRef]
- Coletta, M.; Alayash, A.I.; Wilson, M.T.; Benedetti, P.A.; Evangelista, V.; Brunori, M. Single Cell microspectroscopy reveals that erythrocytes containing hemoglobin-s retain a memory of previous sickling cycles. FEBS Lett. 1988, 236, 127–131. [Google Scholar] [CrossRef]
- Du, E.; Dao, M. Faster sickling kinetics and sickle cell shape evolution during repeated deoxygenation and oxygenation cycles. Exp. Mech. 2019, 59, 319–325. [Google Scholar] [CrossRef]
- Vekilow, P.G. Sickle-cell haemoglobin polymerization: Is it the primary pathogenic event of sickle-cell anaemia? Brit. J. Haematol. 2007, 139, 173–184. [Google Scholar] [CrossRef]
- Borges da Silva, F.A.; Racanelli, A.P.; Lorand-Metze, I.; Metze, K. Fluorescence lifetime imaging is able to recognize different hematopoietic precursors in unstained routine bone marrow films. Cytometry Part A 2021, 99, 641–646. [Google Scholar] [CrossRef]
- Garcia, I.V.A.; Blum, S.A. Polymer Molecular Weight Determination via Fluorescence Lifetime. J. Am. Chem. Soc. 2022, 144, 22416–22420. [Google Scholar] [CrossRef]
- Becker, W. Fluorescence lifetime imaging—Techniques and applications. J. Microsc. 2012, 247, 119–136. [Google Scholar] [CrossRef] [PubMed]
- Borges da Silva, F.A.; Lorand-Metze, I.; Metze, K. Chédiak–Higashi syndrome approached by several different microscopy imaging technologies. Br. J. Haematol. 2020, 189, 1001. [Google Scholar] [CrossRef] [PubMed]
- Chacko, J.V.; Eliceiri, K.W. Auto-fluorescence lifetime imaging of cellular metabolism: Sensitivity toward cell density, pH, intracellular, and intercellular heterogeneity. Cytometry Part A 2019, 95, 56–69. [Google Scholar] [CrossRef] [PubMed]
- Breunig, H.G.; Studier, H.; König, K. Multiphoton excitation characteristics of cellular fluorophores of human skin in vivo. Opt. Express 2010, 18, 7857–7871. [Google Scholar] [CrossRef]
- Wang, H.L.; Liang, X.W.; Gravot, G.; Thorling, C.A.; Crawford, D.H.G.; Xu, Z.P.; Liu, X.; Roberts, M.S. Visualizing liver anatomy, physiology and pharmacology using multiphoton microscopy. J. Biophotonics 2017, 10, 46–60. [Google Scholar] [CrossRef]
- Marcu, L. Fluorescence Lifetime Techniques in Medical Applications. Ann. Biomed. Eng. 2012, 40, 304–331. [Google Scholar] [CrossRef]
- Metze, K.; Borges da Silva, F.A.; Racanelli, A.P. Fluorescence lifetime imaging provides label-free recognition of mucin production in gastrointestinal specimens. Virchows Arch. 2016, 469, S167–S168. [Google Scholar]
- Metze, K.; Borges da Silva, F.A. Autofluorescence imaging is useful for the detection of lymph node metastases in unstained paraffin sections. Virchows Arch. 2017, 471, S249. [Google Scholar]
- Metze, K.; Borges da Silva, F.A.; Racanelli, A.P.; Lorand-Metze, I. Label-free imaging of infectious agents in routine histology and cytology by fluorescence lifetime Imaging (FLIM). Virchows Arch. 2016, 469, S30. [Google Scholar]
- Nagababu, E.; Rifkind, J.M. Formation of fluorescent heme degradation products during the oxidation of hemoglobin by hydrogen peroxide. Biochem. Biophys. Res. Commun. 1998, 247, 592–596. [Google Scholar] [CrossRef]
- Shirshin, E.A.; Evgeny, A.; Yakimov, B.P.; Boris, P.; Rodionov, S.A.; Omelyanenko, N.; Priezzhev, A.V.; Fadeev, V.V. Lademann Formation of hemoglobin photoproduct is responsible for two-photon and single photon-excited fluorescence of red blood cells. Laser Phys. Lett. 2018, 15, 075604. [Google Scholar] [CrossRef]
- Schulte, E. Air drying as a preparatory factor in cytology: Investigation of its influence on dye uptake and dye binding. Diagn. Cytopathol. 1986, 2, 160–167. [Google Scholar]
- Dong, T.; Wan, S.; Fu, Y.; Wang, P. Effects of chemical fixatives on kinetic measurements of biomolecular interaction on cell membrane. J. Membr. Biol. 2024, 257, 131–142. [Google Scholar] [CrossRef] [PubMed]
- Siow, W.; Matthey, F.; Bain, B.J. The significance of irregularly contracted cells and hemighosts in sickle cell disease. Am. J. Hematol. 2017, 92, 966–967. [Google Scholar] [CrossRef]
- Galkin, O.; Pan, W.; Filobelo, L.; Hirsch, R.E.; Nagel, R.L.; Vekilov, P.G. Two-step mechanism of homogeneous nucleation of sickle cell hemoglobin polymers. Biophys. J. 2007, 92, 902–913. [Google Scholar] [CrossRef]
- Jockusch, H.; Voigt, S.; Eberhard, D. Localization of GFP in frozen sections from unfixed mouse tissues: Immobilization of a highly soluble marker protein by formaldehyde vapor. J. Histochem. Cytochem. 2003, 51, 401–404. [Google Scholar] [CrossRef]
- Ojala, T.; Pietikainen, M.; Harwood, D. A comparative study of texture measures with classification based on featured distributions. Pattern Recognit. 1996, 29, 51–59. [Google Scholar] [CrossRef]
- Kaur, N.; Nazir, N. A review of local binary pattern based texture feature extraction. In Proceedings of the 9th International Conference on Reliability, Infocom Technologies and Optimization (Trends and Future Directions) (ICRITO), Noida, India, 3–4 September 2021; pp. 1–4. [Google Scholar]
- Ojala, T.; Pietikainen, M.; Maenpaa, T. Multiresolution gray-scale and rotation invariant texture classification with local binary patterns. IEEE Trans. Pattern Anal. Mach. Intell. 2002, 24, 971–987. [Google Scholar] [CrossRef]
- Scholkopf, B.; Mullert, K.-R. Fisher discriminant analysis with kernels. In Proceedings of the 1999 IEEE Signal Processing Society Workshop Neural Networks for Signal Processing IX, Madison, WI, USA, 23–25 August 1999; pp. 41–48. [Google Scholar]
- Lorand-Metze, I.; Carvalho, M.A.; Metze, K. Relationship between morphometric analysis of nucleolar organizer regions and cell proliferation in acute leukemias. Cytom. J. Int. Soc. Anal. Cytol. 1998, 32, 51–56. [Google Scholar] [CrossRef]
- Cross, E.M.; Chaffin, W.W. Use of the binomial theorem in interpreting results of multiple tests of significance. Educ. Psychol. Meas. 1982, 42, 25–34. [Google Scholar] [CrossRef]

| Control Cases N = 27 | p-Values * Control × not Sickled | Non-Sickled Cells from Patients N = 45 | Sickled Cells from Patients N = 34 | p-Values ** Non-Sickled × Sickled RBCs | |
|---|---|---|---|---|---|
| Mean | 175.689 | 0.31 | 192.343 | 247.568 | 0.000 |
| St. deviation of Mean | 30.050 | 0.61 | 27.702 | 56.240 | 0.000 |
| Entropy | 1.883 | 0.19 | 1.8597 | 1.7884 | 0.033 |
| Skewness | 0.801 | 0.18 | 0.637 | 1.033 | 0.005 |
| LBP | |||||
| Mean | 10.683 | 0.000 | 14.063 | 15.222 | 0.003 |
| St. deviation of Mean | 10.284 | 0.001 | 10.959 | 10.498 | 0.000 |
| Entropy | 1.675 | 0.000 | 1.564 | 1.721 | 0.000 |
| Skewness | 0.649 | 0.000 | −0.1241 | −0.300 | 0.005 |
| Controls N = 270 | p-Values * Control × not Sickled | Patients, not Sickled N = 432 | Patients, Sickled N = 214 | p-Values * Non-Sickled × Sickled RBCs | |
|---|---|---|---|---|---|
| Mean | 175.531 | 0.004 | 193.891 | 253.335 | 0.000 |
| St. deviation of mean | 30.222 | 0.49 | 28.091 | 58.614 | 0.000 |
| 5% | 135.700 | 0.000 | 155.050 | 181.516 | 0.000 |
| 95% | 227.679 | 0.068 | 243.867 | 361.172 | 0.000 |
| Entropy | 1.886 | 0.019 | 1.866 | 1.807 | 0.010 |
| Skewness | 0.787 | 0.072 | 0.630 | 0.950 | 0.000 |
| LBP | |||||
| Mean | 10.683 | 0.000 | 13.981 | 15.097 | 0.000 |
| St. deviation of mean | 10.284 | 0.001 | 10.945 | 10.475 | 0.000 |
| Entropy | 1.675 | 0.000 | 1.567 | 1.766 | 0.002 |
| Skewness | 0.649 | 0.000 | −0.103 | −0.317 | 0.000 |
Disclaimer/Publisher’s Note: The statements, opinions and data contained in all publications are solely those of the individual author(s) and contributor(s) and not of MDPI and/or the editor(s). MDPI and/or the editor(s) disclaim responsibility for any injury to people or property resulting from any ideas, methods, instructions or products referred to in the content. |
© 2024 by the authors. Licensee MDPI, Basel, Switzerland. This article is an open access article distributed under the terms and conditions of the Creative Commons Attribution (CC BY) license (https://creativecommons.org/licenses/by/4.0/).
Share and Cite
Borges da Silva, F.A.; Florindo, J.B.; Mattos, A.C.d.; Costa, F.F.; Lorand-Metze, I.; Metze, K. Accompanying Hemoglobin Polymerization in Red Blood Cells in Patients with Sickle Cell Disease Using Fluorescence Lifetime Imaging. Int. J. Mol. Sci. 2024, 25, 12290. https://doi.org/10.3390/ijms252212290
Borges da Silva FA, Florindo JB, Mattos ACd, Costa FF, Lorand-Metze I, Metze K. Accompanying Hemoglobin Polymerization in Red Blood Cells in Patients with Sickle Cell Disease Using Fluorescence Lifetime Imaging. International Journal of Molecular Sciences. 2024; 25(22):12290. https://doi.org/10.3390/ijms252212290
Chicago/Turabian StyleBorges da Silva, Fernanda Aparecida, João Batista Florindo, Amilcar Castro de Mattos, Fernando Ferreira Costa, Irene Lorand-Metze, and Konradin Metze. 2024. "Accompanying Hemoglobin Polymerization in Red Blood Cells in Patients with Sickle Cell Disease Using Fluorescence Lifetime Imaging" International Journal of Molecular Sciences 25, no. 22: 12290. https://doi.org/10.3390/ijms252212290
APA StyleBorges da Silva, F. A., Florindo, J. B., Mattos, A. C. d., Costa, F. F., Lorand-Metze, I., & Metze, K. (2024). Accompanying Hemoglobin Polymerization in Red Blood Cells in Patients with Sickle Cell Disease Using Fluorescence Lifetime Imaging. International Journal of Molecular Sciences, 25(22), 12290. https://doi.org/10.3390/ijms252212290

